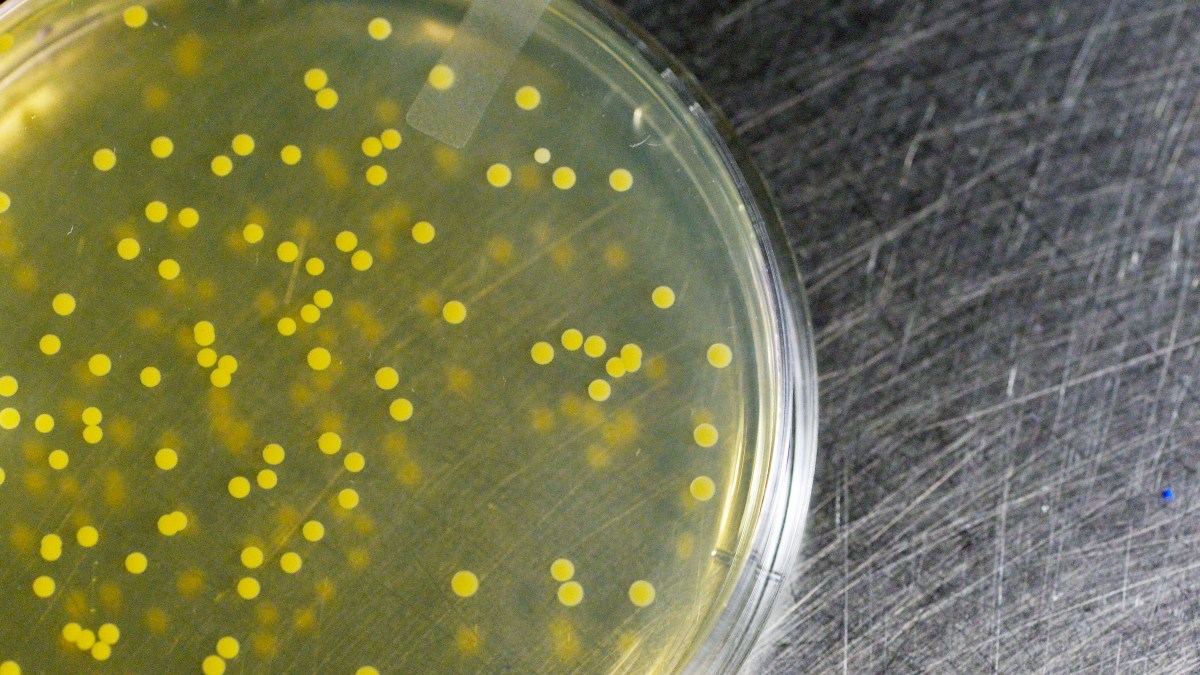

What Coronavirus Looks Like In The Air

How Soon Can We Fly After Covid 19 And What Will It Look Like Airline Ratings
www.airlineratings.com

Coronavirus Inspired Dish At Alinea Draws Backlash Chef Grant Achatz Explains His Intent Chicago Tribune
www.chicagotribune.com

China Sends Ships Planes Over Disputed Seas To Show Strength After Covid 19 Outbreak Voice Of America English
www.voanews.com



:strip_exif(true):strip_icc(true):no_upscale(true):quality(65)/arc-anglerfish-arc2-prod-gmg.s3.amazonaws.com/public/P25AEA6MKZFIHPNLFXQF7PN2XI.jpg)






























/cdn.vox-cdn.com/uploads/chorus_image/image/66585693/onion_guy.0.jpg)